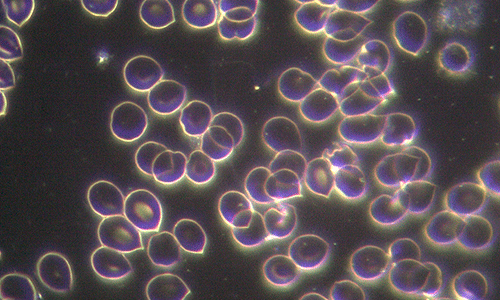
Técnica campo oscuro y fosfenos
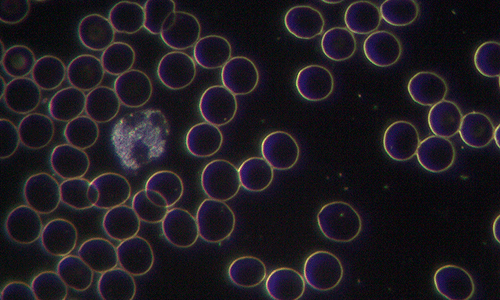
microscopio de campo oscuro y fosfenos
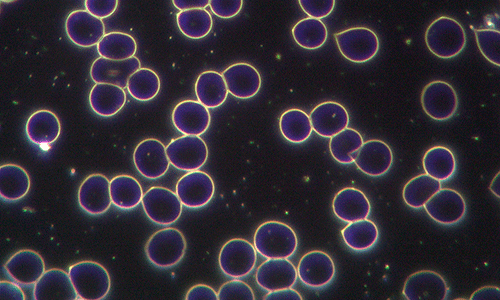
Flujo de información fosfénica y campo oscuro

El análisis de campo oscuro es una técnica de microscopia celular que se ha
convertido en una herramienta invaluable en la prevención y diagnóstico de
enfermedades. Aunque existen varios métodos de diagnóstico en la microscopía
celular morfológica, el campo oscuro ha ido ganando relevancia de manera
significativa. Básicamente, el análisis de campo oscuro se basa en un método de
contraste único. Imagina que una fuerte luz se difracta al incidir sobre el objeto que
deseas observar, como una muestra de sangre. Esta difracción permite que observes
la muestra en contraste con un fondo oscuro, lo que le da el nombre de análisis de
campo oscuro. La microscopía celular de campo oscuro se utiliza para analizar
muestras biológicas sin la necesidad de tinciones. Esto significa que las partes
transparentes de los elementos observados aparecen oscuras, mientras que las no
transparentes se ven brillantes bajo la intensa luz dispersada.
Esta técnica es valiosa no solo por lo que hace, sino por lo que permite hacer. Permite
la transmisión de un flujo de información, capaz de alterar la sangre, lo que
desempeña un papel fundamental en la prevención y diagnóstico de
enfermedades.
Monomorfismo y el pleomorfismo
Para comprender el contexto del análisis de campo oscuro, es importante considerar la
controversia que existe entre dos figuras influyentes en la historia de la microbiología: Louis
Pasteur y Antoine Béchamp. Esta controversia, conocida como la pugna entre el
monomorfismo y el pleomorfismo, arroja luz sobre el análisis de campo oscuro. El
monomorfismo sostiene que los microbios y las bacterias son inmutables, es decir, su
estructura no varía. Además, considera que la sangre y los órganos son entornos estériles en
condiciones ideales. En otras palabras, cuando ocurre una enfermedad, es el resultado de un
ataque externo, una invasión. La agresión externa provoca la enfermedad, y el terreno
biológico tiene una importancia relativa en esta teoría.
Por otro lado, Antoine Béchamp defendía el pleomorfismo. Según esta perspectiva, en todas
las células vivas, ya sean animales o vegetales, se encuentran enzimas que son las unidades
elementales de la vida. Cuando se aísla por completo una muestra biológica de influencias
exteriores, la muestra comienza a fermentar. En consecuencia, el problema se origina dentro
de la propia célula. Por lo tanto, el estado del terreno biológico es fundamental. Por ejemplo,
dependiendo del pH del terreno en el que se encuentren las células, pueden acabar
produciendo hongos.
Günther Enderlein, un investigador influyente, observó endosimbiontes utilizando el
microscopio de campo oscuro. Lo que resultó especialmente relevante fue el hecho de que la
endosimbiosis representa un intercambio genético activo entre la célula y el
microorganismo. En consecuencia, el estado del campo donde ocurre este proceso dinámico
es fundamental y determina, según Enderlein, la evolución microbiana.
Recuperación del concepto endosimbiótico
El centro generador de la energía de la célula son las mitocondrias. Parece que una célula
procariota especializada en obtener energía del oxígeno colaboró con otra. De esta
simbiosis, una proporcionó ATP (trifosfato de adenosina), mientras que la otra proporcionó
el alojamiento. Finalmente, este organismo colaboró con otros aún más grandes y se encargó
de producir energía, lo que llevó al surgimiento de las mitocondrias.
Sin embargo, esta no es la única hipótesis. Algunos científicos sostienen que el origen de la
mitocondria fue parasitario. A pesar de las controversias, parece que se está recuperando lo
que ahora se conoce como la teoría endosimbiótica.
Procedimiento de análisis celular con microscopia de campo oscuro
El centro generador de la energía de la célula son las mitocondrias. Parece que una célula
procariota especializada en obtener energía del oxígeno colaboró con otra. De esta
simbiosis, una proporcionó ATP (trifosfato de adenosina), mientras que la otra proporcionó
el alojamiento. Finalmente, este organismo colaboró con otros aún más grandes y se encargó
de producir energía, lo que llevó al surgimiento de las mitocondrias.
Sin embargo, esta no es la única hipótesis. Algunos científicos sostienen que el origen de la
mitocondria fue parasitario. A pesar de las controversias, parece que se está recuperando lo
que ahora se conoce como la teoría endosimbiótica.
Acción a distancia del fosfeno
La idea de que una imagen de persistencia retiniana, como el fosfeno, pueda salir del cerebro y, aún más
sorprendente, interactuar con el entorno, parece poco convencional. Desde una perspectiva convencional, el fosfeno se considera una experiencia subjetiva y puramente mental, lo que limita su alcance a una percepción privada. Sin embargo, algunas teorías desafían esta noción.
Resumidamente, considerando el fosfeno como algo subjetivo, puramente mental, queda restringido a una percepción privada. Es decir, actualmente y desde la concepción oficial, el fosfeno es puramente una postimagen. Además, una experiencia mental subjetiva siempre es privada. Aunque siempre hay esperanza. Por ejemplo, Freeman John Dyson, matemático y físico teórico dice que: las especulaciones que no comienzan pareciendo locuras carecen de todo futuro.
La posibilidad de que el fosfeno sea un elemento exteriorizable y vehicule flujos de información por un campo, es revolucionaria. En primer lugar, sabemos que el fosfeno no es simplemente una imagen de persistencia retiniana. Un fosfeno, es una mancha luminosa producida cuando se estimula eléctrica, magnética o mecánicamente, la retina o el córtex visual. Sin embargo, gracias a los descubrimientos del Dr. Lefebure, tenemos la certeza que son algo más. Los fosfenos son, además, manifestaciones de la absorción de la energía de la luz convertida en energía cerebral.
Más aún, el fosfeno es exteriorizable, es decir, literalmente toca la realidad externa al cerebro. Además, postulo todavía un concepto con mayor calado: la consciencia personal se extiende muy fácilmente cuando el fosfeno está presente.
En conclusión, la supuesta imagen de persistencia, es en realidad una energía que emana del cerebro. Como consecuencia, el fosfeno facilita el intercambio de información a través de un campo subyacente.
Experiencia de exteriorización del fosfeno sobre una muestra de sangre y su verificación con el análisis de campo oscuro
El 17 de octubre de 2019, se llevó a cabo una experiencia para explorar la exteriorización de la consciencia a través del fosfeno. La persona que actuó como sujeto pasivo fue María Purificación Escrivà Savall. Diez sujetos activos participaron en la proyección de fosfenos. El análisis de campo oscuro fue supervisado y valorado por David Jiménez Barrieras, un experto en neuroanatomía y neurofisiología,
con experiencia en técnicas como el microscopio de campo oscuro.
A lo largo de la experiencia, se llevaron a cabo extracciones de sangre y proyecciones de fosfenos. Se compartieron instrucciones y análisis a través de comunicación verbal y mensajes entre los participantes. Los resultados del análisis de campo oscuro revelaron cambios significativos en las muestras de sangre, lo que indica que algo ocurrió durante la experiencia. Esto sugiere que un elemento sutil, no físico, como el fosfeno, puede modificar sustancialmente elementos físicos, emociones y estados sutiles.
A continuación, podrá encontrar las informaciones que recibieron las personas encargadas de exteriorizar la energía del fosfeno. Es decir, los sujetos activos. Los participantes fueron informados el día anterior a las 15:39 por medio de un audio enviado al chat conjunto. Después de la primera y segunda extracciones, Purificación Escrivà realiza un fosfeno. Por lo que la transmisión del flujo de información entre pasivo y activos se ve incrementado.
En mi caso, permanecí en el lugar de la experiencia todo el tiempo que duró la misma. Físicamente proyecté sobre la muestra y el pasivo. La proyección sobre la muestra situada en el microscopio de campo oscuro fue con los ojos abiertos. Posé el fosfeno en la muestra de sangre viva a las 9:30 durante unos 30 segundos. Finalmente, a las 9:43 proyecté durante dos minutos con los ojos cerrados, sobre la zona hepática de Purificación.
Cronología de las instrucciones para las proyecciones del fosfeno
La experiencia se llevó a cabo siguiendo una serie de instrucciones y etapas específicas. Las
extracciones de sangre se realizaron en momentos determinados, y las proyecciones
fosfénicas se focalizaron en objetivos concretos para influir en la salud de Purificación
Escrivà. Los sujetos activos participaron de manera coordinada, transmitiendo energía a
través de los fosfenos.
A las 9:14
Primera extracción para el análisis de campo oscuro. Continuamos con el trabajo personal. Desde las nueve de la mañana, incluso antes en algún caso, los pasivos estaban realizado fosfenos.
A las 9:15
Continuamos con el trabajo personal. Es decir, se insiste en que todavía no se proyecta, se acumula energía cerebral mediante el fosfeno.

A las 9:19
Primera muestra de sangre. Se envía una imagen con la primera muestra al chat del grupo de sujetos activos.
A las 9:22
Función hepática mal. Acidez intracelular. Falta de oxígeno en las células. Este mensaje se envía tras valorar David Jiménez la muestra con el microscopio de campo oscuro.
A las 9:24
Proyectar: Hígado limpio. PH intracelular equilibrado. Oxigenación. Campo Emocional equilibrado. Es decir, se informa del flujo de información que debe acompañar la proyección del fosfeno.
A las 9:40
Segunda extracción, mejora muy clara, hepática y de la oxigenación celular. No, de la acidificación. Se informa a los activos mediante un video del estado de la sangre tras sus proyecciones.
A las 9:41
Nos centramos en reducirla. Por eso se focalizan todavía más las proyecciones. En consecuencia, se reorienta el flujo de información que llega a Purificación Escrivà.
A las 9:42
Pensamos en bicarbonato sódico bañando a María Purificación Escrivà Savall. Puesto que la acidificación todavía se manifiesta se ofrece una imagen mental a los activos.
A las 9:55
Tercera Extracción. Muchísimo movimiento celular, baja la acidez. También se acompaña la comunicación con un video de imagen del microscopio de campo oscuro.
A las 9:59
Muchísimo movimiento, baja acidez. Se comparte con los activos los comentarios del especialista en análisis de campo oscuro David Jiménez.
A las 10:02
Muy bueno, muchas gracias. Finalmente se agradece a los activos su esfuerzo.
Conclusiones
Como resultado de las imágenes parece obvio que se ha producido un cambio durante el análisis de campo oscuro. Por lo tanto, algo ha debido suceder en los escasos minutos trascurridos entre las extracciones de las gotas de sangre. Parece que debiera ser algo capaz de cambiar drásticamente la morfológica y el comportamiento celular. También, se produce una variación significativa en el medio. Sin embargo, la persona que realiza la experiencia se encuentra, durante todo el proceso, estirada en una camilla. No ingiere nada y no interactúa físicamente con nada ni con nadie excepto mediante la comunicación verbal. Incluso se mantiene en silencio y reposo la mayor parte del tiempo. Especialmente relevante es que, la única variable entre las extracciones del análisis de campo oscuro son las proyecciones fosfénicas.
Probablemente, son muchos los factores que escapan a un control exhaustivo de las variables. Sin embargo, puede inferirse que la variable introducida conscientemente, es decir, el fosfeno, intervino en la experiencia. Como consecuencia, las implicaciones terapéuticas y ontológicas son profundas.
En conclusión, si como parece por la experiencia, un elemento sutil, no físico, es capaz de modificar sustancialmente uno físico, podríamos estar frente a un enlace entre la consciencia y el mundo de las cosas.
Es decir, el fosfeno es capaz de canalizar flujos de información y modificar con ellos elementos físicos, emociones y estados sutiles.
Es posible que, en algún momento, aprendamos a colaborar para avanzar en vez de imponer. Así como hacen los microorganismos y como no supieron hacer Pasteur y Bechamp. Tal vez Bechamp y Pasteur, no fueran a encolerizarse alguno de los incondicionales que les apoyan. Las trincheras de las ideas las crean los hombres, así como crean fronteras. Sin embargo, ni las ideas ni la tierra sabe de unas ni de otras.
Participantes en la experiencia del análisis de campo oscuro de la sangre tras la proyección fosfénica
El encargado del control y valoración del análisis de campo oscuro fue David Jiménez Barrieras. Master en Neuroanatomía y Neurofisiología con el sistema de Biofeedback SCIO por la Universidad de Medicina y Farmacia de Timișoara. Naturópata especialista en Bioenergética y Biorresonancia. Para saber más sobre la técnica del campo oscuro puede contactar con David aquí.
La persona que actuó como sujeto pasivo fue María Purificación Escrivà Savall. Finalmente, los sujetos activos encargados de las proyecciones fueron: Gemma Mercier, Adriana Sorina, Genma García, Arantxa Palacios, Natalia Nuria Martínez, Mercedes Fernández, Antonio Pérez, Miguel Rada, Alex Quintana y Juan Carlos Arroyo.
Diferencias entre el campo claro y el campo oscuro
El campo claro y el campo oscuro son dos técnicas de observación microscópica que
ofrecen enfoques contrastantes para el estudio de muestras biológicas. El campo claro
es una técnica de observación microscópica convencional en la que la muestra se
ilumina directamente desde la parte inferior, y se recogen las estructuras que difractan
la luz para formar la imagen. En contraste, el campo oscuro utiliza una técnica de
iluminación especial en la que la luz se desvía alrededor de la muestra, de modo que
solo se capturan las estructuras que alteran significativamente el camino de la luz.
El campo claro es útil para observar detalles de muestras densas y teñidas, ya que
proporciona una imagen nítida y brillante. Por otro lado, el campo oscuro es
particularmente adecuado para observar estructuras transparentes o muestras vivas,
ya que resalta los contornos y las partículas en movimiento que, de lo contrario,
podrían pasar desapercibidos en un campo claro. La elección entre campo claro y
campo oscuro depende de la naturaleza de la muestra y los detalles que se deseen
observar, lo que brinda a los investigadores opciones versátiles para el análisis
microscópico.
Francesc Celma i Girón
Director de Dr. Lefebure Methods®
